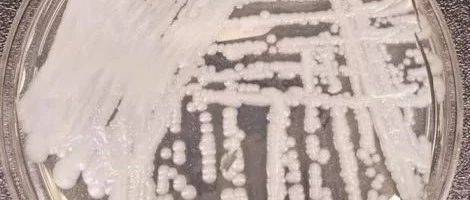

北京时间8月8日消息,据国外媒体报道,一项关于致命真菌感染神秘起源的最新研究表明,全球气候变暖可能是“罪魁祸首”!
耳道假丝酵母菌(Candida auris)是一种致命病菌,可以杀死与病菌携带者密切接触的任何人,2009年,全球首例该病菌感染患者出现在日本,该患者耳部感染,之后耳道假丝酵母菌陆续出现在亚洲、非洲和南美洲,不同地区的感染患者没有明确的关联性,当时该病菌被认为非常神秘,没有人能找出感染原因。
最大的谜团是同一种真菌如何在几乎同一时间出现在三个不同的大陆地区,而它们的基因性却各不相同。

在研究耳道假丝酵母菌的过程中,研究团队观察了这种真菌的近亲生物,他们注意到大多数真菌无法在人体温度条件下生存,这使得他们相信该真菌已适应了更高的温度环境。
绝大多数真菌能在外界温度条件下生长良好,仅有少数真菌可以承受人体温度,令人担忧的是,全球气候转暖导致环境温度升高,最终一些真菌突破了温度限制条件,人体温度对于真菌而言非常高,通常会使大多数真菌远离我们的身体,如果没有这些人体防御机制,耳道假丝酵母菌和其他真菌会感染并杀死人类。
迄今为止,印度、南非、俄罗斯等30多个国家均报导发现了耳道假丝酵母菌感染病例,依据美国疾病控制与预防中心的数据,超过三分之一的病菌携带者最终死于耐药性疾病,这是美国一种非常罕见的疾病,美国大约有680例确诊病例。
尽管如此,专家们还是对耳道假丝酵母菌感到担忧,这种病菌很难探测发现,因为它经常出现在因其他感染而患病的患者身体,其症状包括:对常规抗生素治疗无效的发烧和发冷,免疫系统受损的人群更易受到攻击,而医院爆发的疫情会出现混乱性和隐蔽性,世界各国政府通常对制造恐慌的疫情持谨慎态度,会选择不公开此类事件。
这种病菌对于卫生工作者而言尤其令人担忧,他们在治疗这种疾病时可能会担心自己的安全,不想在工作期间感染这种传染疾病,也不希望将该疾病传染给其他患者,2018年5月,布鲁克林一家医院一位接受腹部手术的老年患者感染了耳道假丝酵母菌,90天之后死亡,从这位死者污染的医院病房中清除所有真菌是非常难的,以至于该医院启用特殊清洁设备,不得不拆除一些天花板和地砖。
更令人恐惧的是:大多数已知耳道假丝酵母菌对于治疗真菌感染的3种药物中至少有一种具有耐药性,数据表明,超过三分之一的菌株对两种真菌感染治疗药物具有抗药性,有些菌株似乎对3种真菌感染治疗药物都具有抗药性。
这项研究结果表明,人类可能即将面临着其他新的疾病,这些疾病也是由适应更温暖气候的真菌引起的,深入研究将帮助我们理解耳道假丝酵母菌的来源,并帮助科学家研究如何对抗它们。
来源:新浪科技